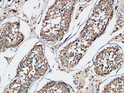
Immunohistochemical analysis of paraffin-embedded Human testis. 1, Antibody was diluted at 1:200 (4°C overnight). 2, High-pressure and temperature EDTA, pH8.0 was used for antigen retrieval. 3, Secondary antibody was diluted at 1:200 (room temperature, 30min).

| Post Translational Modifications | S-Nitrosylation down-regulates its E3 ubiquitin-protein ligase activity. Autoubiquitinated. Ubiquitinated by TRIM32.leading to proteasomal degradation. |
| Function | Multi-functional protein which regulates not only caspases and apoptosis, but also modulates inflammatory signaling and immunity, copper homeostasis, mitogenic kinase signaling, cell proliferation, as well as cell invasion and metastasis. Acts as a direct caspase inhibitor. Directly bind to the active site pocket of CASP3 and CASP7 and obstructs substrate entry. Inactivates CASP9 by keeping it in a monomeric, inactive state. Acts as an E3 ubiquitin-protein ligase regulating NF-kappa-B signaling and the target proteins for its E3 ubiquitin-protein ligase activity include: RIPK1, RIPK2, MAP3K2/MEKK2, DIABLO/SMAC, AIFM1, CCS, PTEN and BIRC5/survivin. Acts as an important regulator of innate immunity by mediating 'Lys-63'-linked polyubiquitination of RIPK2 downstream of NOD1 and NOD2, thereby transforming RIPK2 into a scaffolding protein for downstream effectors, ultimately leading to activation of the NF-kappa-B and MAP kinases signaling. 'Lys-63'-linked polyubiquitination of RIPK2 also promotes recruitment of the LUBAC complex to RIPK2. Regulates the BMP signaling pathway and the SMAD and MAP3K7/TAK1 dependent pathways leading to NF-kappa-B and JNK activation. Ubiquitination of CCS leads to enhancement of its chaperone activity toward its physiologic target, SOD1, rather than proteasomal degradation. Ubiquitination of MAP3K2/MEKK2 and AIFM1 does not lead to proteasomal degradation. Plays a role in copper homeostasis by ubiquitinating COMMD1 and promoting its proteasomal degradation. Can also function as E3 ubiquitin-protein ligase of the NEDD8 conjugation pathway, targeting effector caspases for neddylation and inactivation. Ubiquitinates and therefore mediates the proteasomal degradation of BCL2 in response to apoptosis. Protects cells from spontaneous formation of the ripoptosome, a large multi-protein complex that has the capability to kill cancer cells in a caspase-dependent and caspase-independent manner. Suppresses ripoptosome formation by ubiquitinating RIPK1 and CASP8. Acts as a positive regulator of Wnt signaling and ubiquitinates TLE1, TLE2, TLE3, TLE4 and AES. Ubiquitination of TLE3 results in inhibition of its interaction with TCF7L2/TCF4 thereby allowing efficient recruitment and binding of the transcriptional coactivator beta-catenin to TCF7L2/TCF4 that is required to initiate a Wnt-specific transcriptional program. |
| Protein Name | E3 Ubiquitin-Protein Ligase XiapBaculoviral Iap Repeat-Containing Protein 4Iap-Like ProteinIlpHilpInhibitor Of Apoptosis Protein 3Iap-3Hiap-3Hiap3Ring-Type E3 Ubiquitin Transferase XiapX-Linked Inhibitor Of Apoptosis ProteinX-Linked Iap |
| Database Links | Reactome: R-HSA-111459Reactome: R-HSA-111463Reactome: R-HSA-111464Reactome: R-HSA-111469Reactome: R-HSA-3769402Reactome: R-HSA-5213460Reactome: R-HSA-5357786Reactome: R-HSA-5357905Reactome: R-HSA-5357956Reactome: R-HSA-5675482Reactome: R-HSA-8948747Reactome: R-HSA-8948751Reactome: R-HSA-9627069 |
| Cellular Localisation | CytoplasmNucleusTle3 Promotes Its Nuclear Localization |
| Alternative Antibody Names | Anti-E3 Ubiquitin-Protein Ligase Xiap antibodyAnti-Baculoviral Iap Repeat-Containing Protein 4 antibodyAnti-Iap-Like Protein antibodyAnti-Ilp antibodyAnti-Hilp antibodyAnti-Inhibitor Of Apoptosis Protein 3 antibodyAnti-Iap-3 antibodyAnti-Hiap-3 antibodyAnti-Hiap3 antibodyAnti-Ring-Type E3 Ubiquitin Transferase Xiap antibodyAnti-X-Linked Inhibitor Of Apoptosis Protein antibodyAnti-X-Linked Iap antibodyAnti-XIAP antibodyAnti-API3 antibodyAnti-BIRC4 antibodyAnti-IAP3 antibody |
Information sourced from Uniprot.org

![Western blot analysis of lysates from wild type (WT) and XIAP knockout (KO) 293T cells, using [KO Validated] XIAP Rabbit monoclonal antibody (STJ11104809) at 1:5000 dilution. Secondary antibody: HRP Goat Anti-Rabbit IgG (H+L) (STJS000856) at 1:10000 dilution. Lysates/proteins: 25 Mu g per lane. Blocking buffer: 3% nonfat dry milk in TBST. Detection: ECL Basic Kit. Exposure time: 90s. Western blot analysis of lysates from wild type (WT) and XIAP knockout (KO) 293T cells, using [KO Validated] XIAP Rabbit monoclonal antibody (STJ11104809) at 1:5000 dilution. Secondary antibody: HRP Goat Anti-Rabbit IgG (H+L) (STJS000856) at 1:10000 dilution. Lysates/proteins: 25 Mu g per lane. Blocking buffer: 3% nonfat dry milk in TBST. Detection: ECL Basic Kit. Exposure time: 90s.](https://cdn11.bigcommerce.com/s-zso2xnchw9/images/stencil/600x533/products/177453/369205/STJ11104809_1__99455.1713134693.jpg?c=1)